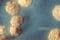

Gram-positif adalah bakteri yang mempertahankan zat warna kristal violet sewaktu proses pewarnaan Gram sehingga akan berwarna biru atau ungu di bawah mikroskop.
Sumber: Lihat artikel asli di Wikipedia

Gram-positif adalah bakteri yang mempertahankan zat warna kristal violet sewaktu proses pewarnaan Gram sehingga akan berwarna biru atau ungu di bawah mikroskop.[1]
Di sisi lain, bakteri gram-negatif akan berwarna merah atau merah muda.[1] Perbedaan keduanya didasarkan pada perbedaan struktur dinding sel yang berbeda dan dapat dinyatakan oleh prosedur pewarnaan Gram.[2] Prosedur ini ditemukan pada tahun 1884 oleh ilmuwan Denmark bernama Christian Gram dan merupakan prosedur penting dalam klasifikasi bakteri.[3]
Bakteri gram positif seperti Staphylococcus aureus (bakteri patogen yang umum pada manusia) hanya mempunyai membran plasma tunggal yang dikelilingi dinding sel tebal berupa peptidoglikan.[2] Sekitar 90 persen dari dinding sel tersebut tersusun atas peptidoglikan sedangkan sisanya berupa molekul lain bernama asam teikhoat.[1] Di sisi lain, bakteri gram negatif (seperti E. coli) memiliki sistem membran ganda di mana membran pasmanya diselimuti oleh membran luar permeabel.[2] Bakteri ini mempunyai dinding sel tebal berupa peptidoglikan, yang terletak di antara membran dalam dan membran luarnya.[2]
Berikut ini adalah karakteristik dari bakteri Gram positif dan negatif. Prescott LM, Harley JP, Klein DA. 2002. Microbiology. 5th Ed. Boston: McGraw-Hill.
| Karakteristik | Gram positif | Gram negatif |
|---|---|---|
| Dinding sel | Homogen dan tebal (20-80 nm) serta sebagian besar tersusun dari peptidoglikan. Polisakarida lain dan asam teikoat dapat ikut menyusun dinding sel. | Peptidoglikan (2-7 nm) di antara membran dalam dan luar, serta adanya membran luar (7-8 nm tebalnya) yang terdiri dari lipid, protein, dan lipopolisakarida |
| Bentuk sel | Bulat, batang, atau filamen | Bulat, oval, batang lurus atau melingkar seperti tanda koma, heliks atau filamen; beberapa mempunyai selubung atau kapsul |
| Reproduksi | Pembelahan biner | Pembelahan biner, kadang-kadang pertunasan |
| Metabolisme | kemoorganoheterotrof | Fototrof, kemolitoautotrof, atau kemoorganoheterotrof |
| Motilitas | Kebanyakan nonmotil, bila motil tipe flagelanya adalah petritrikus (petritrichous) | Motil atau nonmotil. Bentuk flagela dapat bervariasi-polar, lopotrikus (lophtrichous), petritrikus (petritrichous). |
| Anggota tubuh (apendase) | Biasanya tidak memiliki apendase | Dapat memiliki pili, fimbriae, tangkai |
| Endospora | Beberapa grup dapat membentuk endspora | Tidak dapat membentuk endospora |
Untuk keterangan lebih lanjut dapat dilihat pada gambar di bawah ini.

Berikut ini adalah klasifikasi dari bakteri Gram positif.

Berikut ini adalah penyakit-penyakit yang dapat ditimbulkan bakteri Gram positif dan negatif.[4]:
| Gram | Genus | Penyakit |
|---|---|---|
| Gram positif |
| |
| Gram negatif |
| |